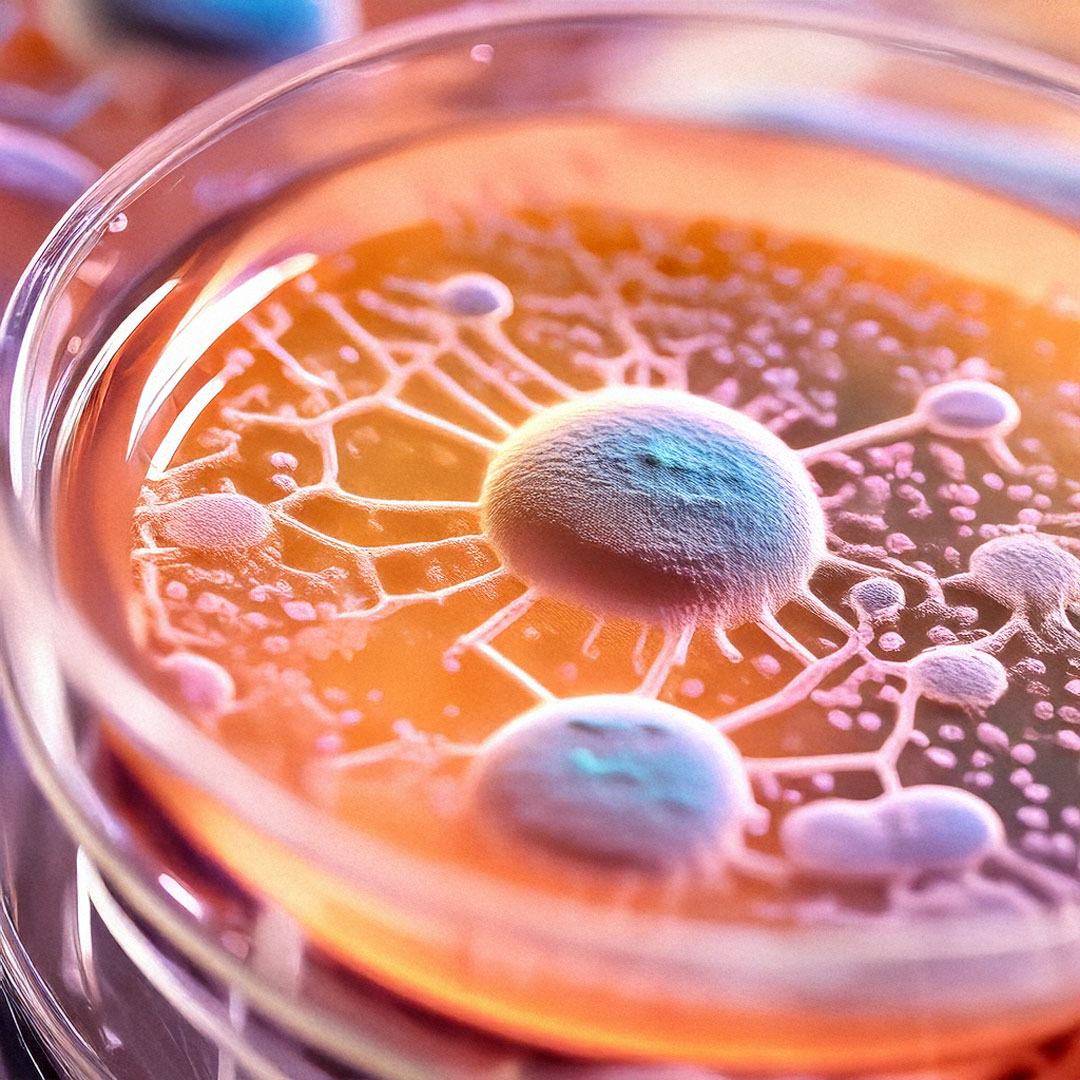
Project
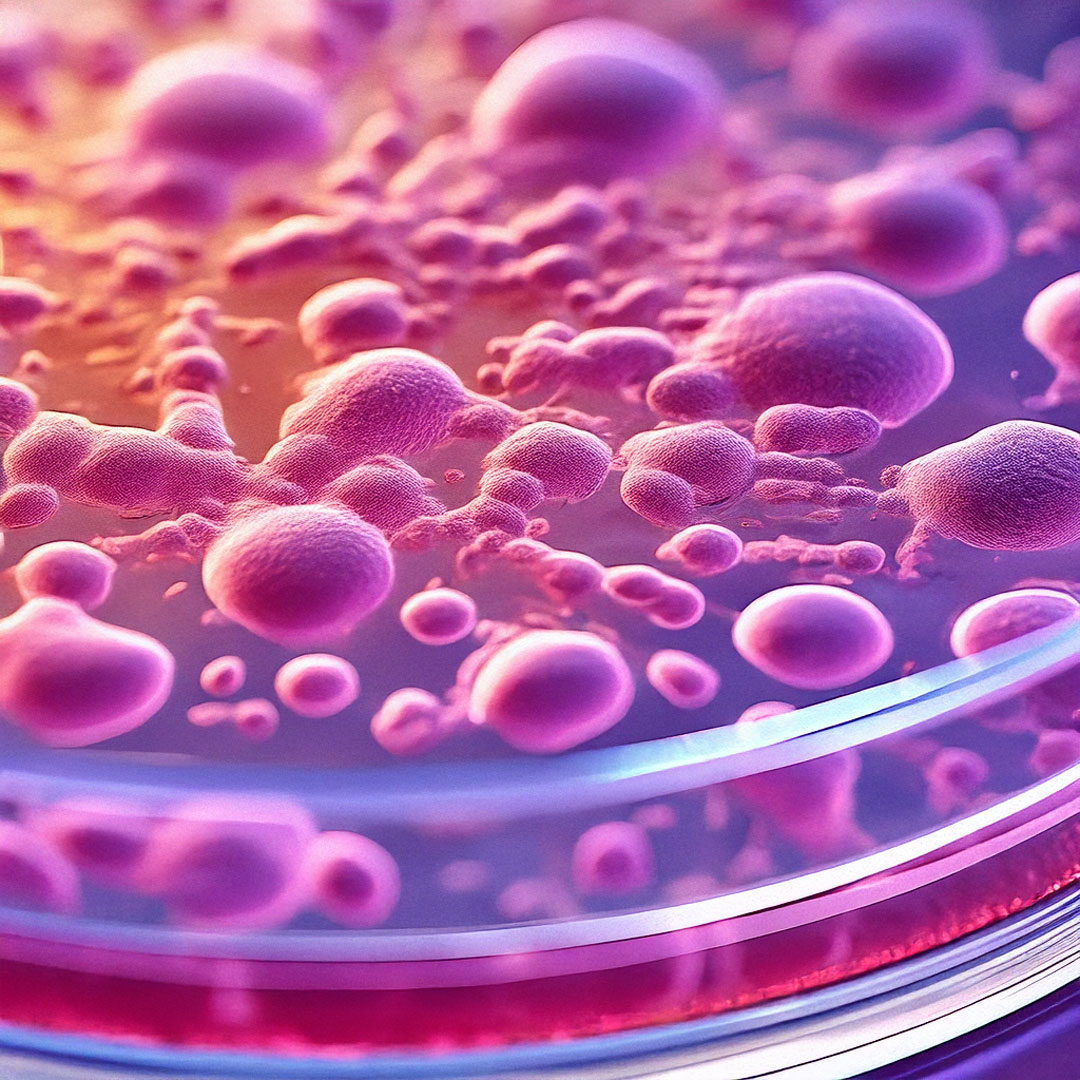
image

Innovating Healthcare Through Biotechnology
ABRP is transforming human healthcare with advanced, non-invasive solutions for regenerative medicine, metabolic health, and disease prevention. Our biotech innovations focus on natural, bioactive compounds that accelerate healing, enhance immunity, and support long-term well-being, bridging the gap between science and real-world healthcare applications.
Scientific Data
Breakthroughs in Cellular Regeneration
Bioactive Healing Technology
Harnessing nutrigenomics and regenerative medicine, ABRP's bioactive compounds enhance cellular repair and wound healing by stimulating key metabolic pathways and gene expression.

Metabolic Health Optimization
Our formulations support organ function, cardiovascular health, and immune balance, promoting natural healing and disease resistance through targeted cellular nutrition.
Benefits of Human Healthcare Innovations
Pioneering Non-Invasive TherapeuticsABRP’s human healthcare solutions leverage the power of biotechnology to enhance recovery, boost immunity, and promote overall health. Our research-backed formulations are safe, effective, and designed for long-term wellness.
Get In Touch
Biotech Research in Human Health
ABRP is currently engaged in research and development of healthcare solutions using bioactive compounds and nutrigenomics technology. The focus is on non-invasive wound healing, organ regeneration, and cardiac support.

Status:
- ✅ Products are still under research
- ✅ Not officially approved for release
- ✅ Undergoing clinical trials
